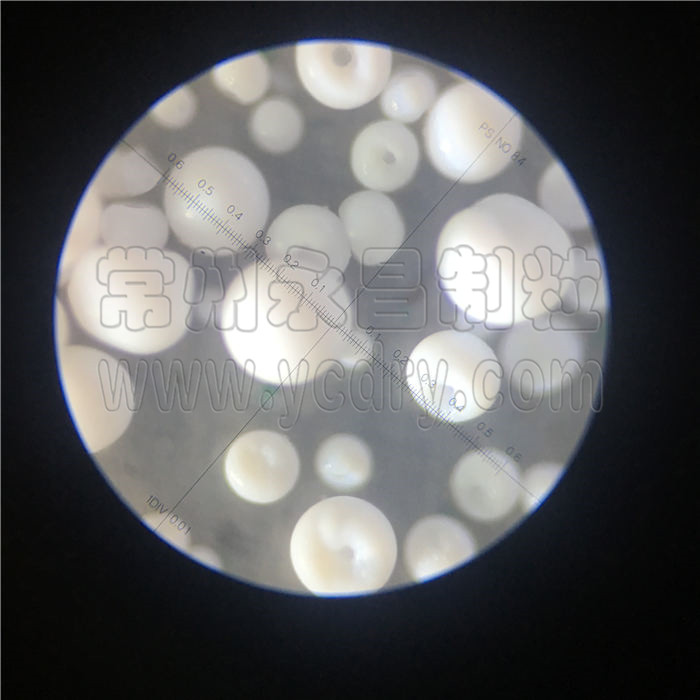
246天天免费资料网

江苏省常州市金坛区儒林镇园区西路98号7幢
邮编:213116
联系人:成经理
手机:13806126909
电话:0519-88911909 88912909
传真:0519-88913909
邮箱:yc@ycdry.com
网址:
氧化镁颗粒压力喷雾造粒塔 空心颗粒试验成功
免费提供小量试验,200ml可试料,进风温度100-260度。也可做中试生产或代加工。
压力喷雾造粒干燥塔是采用进口雾化器借助高压均质机的压力将溶液或浆状的物料雾化成细微液滴,使表面积显著增大,经与热风进行充分热交换得以快速干燥(十几秒至几十秒),从而得到粉体或细小球形颗粒产品的设备。